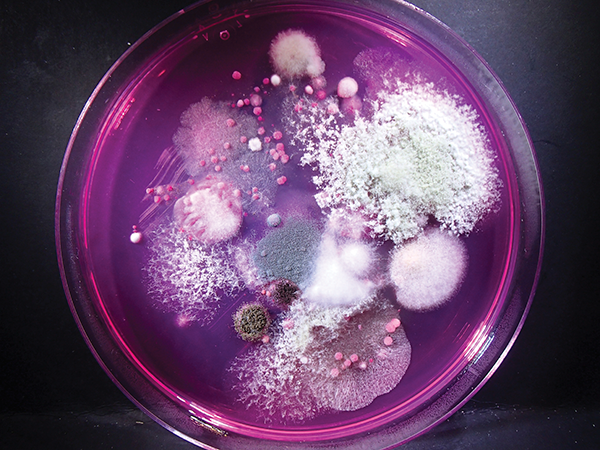

Astronomy & Astrophysics
Research at the Astronomy & Astrophysics Research Lab (AARL) spans from understanding the early solar system and our own beginnings to the origin of galaxies in the Universe.
Genomics & Microbiology
The Genomics and Microbiology unit uses cutting-edge genomic technologies to explore the microscopic world of DNA inside a diversity of species from primates to planthopper insects, and the microbes associated with them.

Geology
The Geology unit conducts experimental, analytical and field-based research in Mineralogy and Geochemistry, with a focus on apatite phases and the geology of North Carolina.

Herpetology
The Herpetology unit conducts collections- and field-based research on the diversity, distributions, natural history, evolutionary relationships, and conservation of amphibians and reptiles in North Carolina and around the world.

Ichthyology
Why are fishes so diverse? From the sunfish and gars of North Carolina, to the enigmatic species of Antarctica and the deep-sea, our staff investigate the factors that have generated and continue to maintain this amazing biodiversity using an integrative approach that combines field, laboratory, and collections based research.

Malacology
The primary foci of the Malacology research unit are freshwater bivalves, freshwater gastropods, and the terrestrial gastropods and marine mollusks of North Carolina.

Mammalogy
Researchers in the Mammalogy unit study the mammals of North Carolina and beyond with new field work, laboratory, and collections based research.

Non-molluscan Invertebrates Zoology
Non-molluscan Invertebrate Zoology encompasses active research being undertaken by several Units and Laboratories throughout the Museum. Topics and fields of study vary widely, and include astacology, entomology, and paleontology.

Ornithology
The Ornithology unit maintains an active field research program involving banding, radio telemetry, field surveys, and specimen collection and preparation.

Paleontology
The paleontology unit maintains an active research program consisting of staff, students, interns, postdoctoral research scholars, volunteers, and adjunct researchers. Collectively, our staff cares for a regionally impactful and globally unique fossil collection that is growing in number, reputation, visibility, and usage. Our research garners worldwide recognition, and we strive to serve the public through educational outreach and programming.

Veterinary Sciences
Veterinary Sciences staff are active in primary research, publication, participation in professional training and conferences, and grant submissions.

